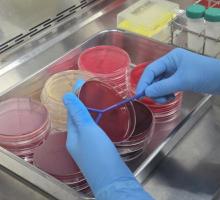

| 전라남도, 2025년 농촌에서 살아보기 우수사례 경진대회 개최 ‘농촌에서 살아보기’ 우수사례 전남 2곳 선정 진도 남도전원한옥마을 우수상·장성 별내리마을 입상 |
| 2025년 12월 05일(금) 17:41 |
|
|
농식품부는 매년 귀농귀촌 포털 ‘그린대로’에 등록된 농촌에서 살아보기 운영 마을을 대상으로 체험프로그램 구성의 독창성, 운영 방식, 참가자 활동 내역, 참가자 만족도, 귀농어귀촌 실적 등을 종합 평가하고 있다.
올해는 전국 99개 마을 중 7개 시·도에서 18개 마을이 참가했으며, 서면 심사를 통과한 10개 중 상위 5개 마을을 대상으로 발표심사를 한 결과 진도 임회면 남도전원한옥마을이 우수상, 장성 별내리마을이 입상으로 선정됐다.
진도 남도전원한옥마을은 2013년 조성돼 주민의 80%가 도시 출신 귀촌자로 구성됐다. 13개 주택이 농어촌민박업소로 등록됐으며, 마을 이해 프로그램, 지역 특색을 살린 국악·영농 체험, 지역 축제·문화예술 행사 참여 등 활동으로 참여자의 만족도를 높였다.
특히 기수별로 군청 관계자와의 정기 간담회를 개최해 정책 안내와 정착 정보를 제공한 결과, 참여자 중 39%가 실제 전입하는 우수한 성과를 보여 심사위원들의 큰 호평을 받았다.
최종민 전남도 인구정책과장은 “전남에서 살아보기 사업은 예비 귀농어귀촌인에게 전남의 매력을 직접 느껴보게 하는 사업이다”며 “앞으로도 다양한 체험프로그램을 제공하고 주거 등 안정적 정착을 위한 맞춤형 귀농어귀촌 정책을 확대하겠다”고 말했다.
시상식은 오는 17일 귀농귀촌 통합 성과·정책 공유대회에서 진행되며, 최우수상 100만 원, 우수상 80만 원, 장려상 40만 원, 입상 30만 원의 포상금이 수여된다.
농촌에서 살아보기 사업은 전남도가 2019년 전국 최초로 추진했으며, 농림축산식품부가 2021년 신규사업으로 벤치마킹해 전국으로 확대됐으나, 2024년부터는 국비 지원이 중단돼 각 시·도에서 자체 사업으로 추진하고 있다.
| |||||||||||